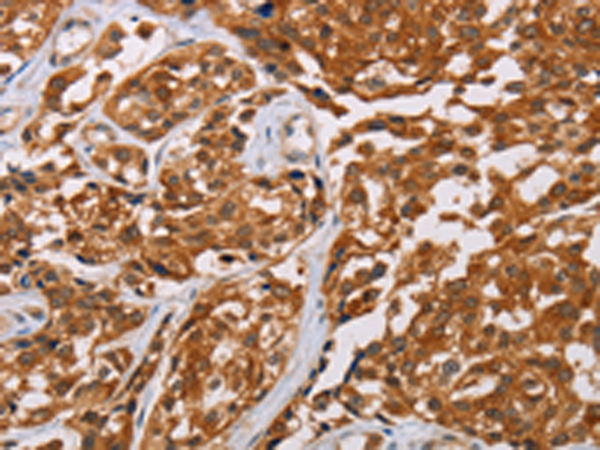

中文名稱: 兔抗CRYAB多克隆抗體
|
Background: |
Crystallins are separated into two classes: taxon-specific, or enzyme, and ubiquitous. The latter class constitutes the major proteins of vertebrate eye lens and maintains the transparency and refractive index of the lens. Since lens central fiber cells lose their nuclei during development, these crystallins are made and then retained throughout life, making them extremely stable proteins. Mammalian lens crystallins are divided into alpha, beta, and gamma families; beta and gamma crystallins are also considered as a superfamily. Alpha and beta families are further divided into acidic and basic groups. Seven protein regions exist in crystallins: four homologous motifs, a connecting peptide, and N- and C-terminal extensions. Alpha crystallins are composed of two gene products: alpha-A and alpha-B, for acidic and basic, respectively. Alpha crystallins can be induced by heat shock and are members of the small heat shock protein (sHSP also known as the HSP20) family. They act as molecular chaperones although they do not renature proteins and release them in the fashion of a true chaperone; instead they hold them in large soluble aggregates. Post-translational modifications decrease the ability to chaperone. These heterogeneous aggregates consist of 30-40 subunits; the alpha-A and alpha-B subunits have a 3:1 ratio, respectively. Two additional functions of alpha crystallins are an autokinase activity and participation in the intracellular architecture. Alpha-A and alpha-B gene products are differentially expressed; alpha-A is preferentially restricted to the lens and alpha-B is expressed widely in many tissues and organs. Elevated expression of alpha-B crystallin occurs in many neurological diseases; a missense mutation cosegregated in a family with a desmin-related myopathy. |
|
Applications: |
ELISA, WB, IHC |
|
Name of antibody: |
CRYAB |
|
Immunogen: |
Fusion protein of human CRYAB |
|
Full name: |
crystallin, alpha B |
|
Synonyms: |
CRYA2; CTPP2; HSPB5; CMD1II |
|
SwissProt: |
P02511 |
|
ELISA Recommended dilution: |
2000-5000 |
|
IHC positive control: |
Human esophagus cancer |
|
IHC Recommend dilution: |
25-100 |
|
WB Predicted band size: |
20 kDa |
|
WB Positive control: |
Mouse heart and human chromaffin cells tumor tissue, mouse muscle tissue |
|
WB Recommended dilution: |
500-2000 |

購物車
購物車 幫助
幫助
 021-54845833/15800441009
021-54845833/15800441009
